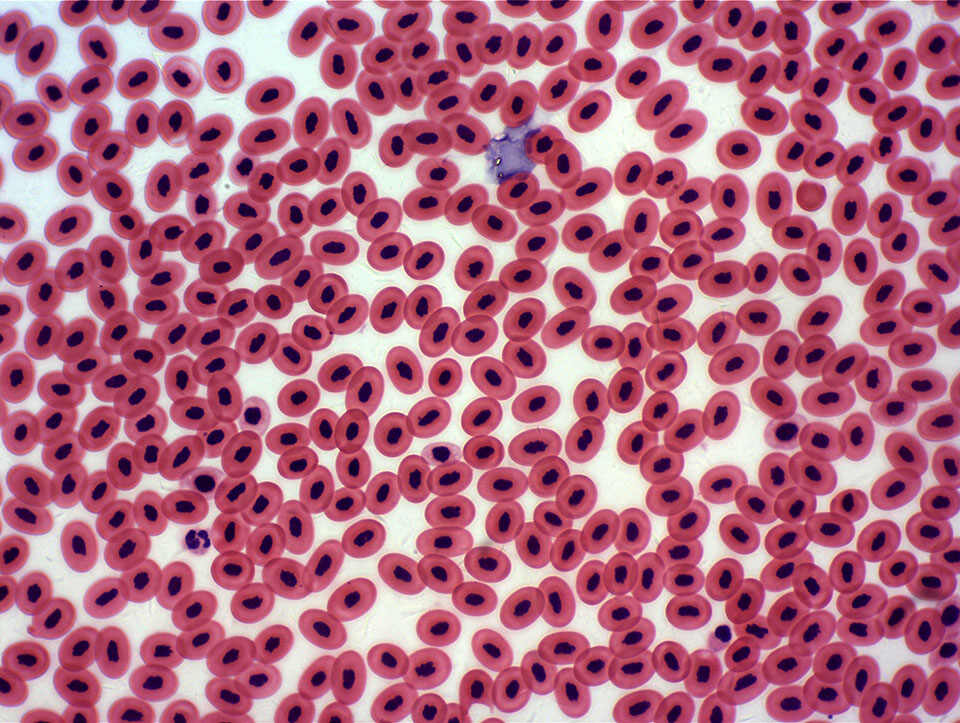

发布成功

一、特点:
(1)可搭配Aptina、OV或BYD、格科微等国产CMOS的全系主流COMS/CCD。
(2)APP支持安卓手机/平板,USB2.0/3.0接口高速数据传输。
(3)支持分辨率切换、自动/手动曝光、自动白平衡、RGB增益、Gamma、锐度、 饱和度等参数调节。
(4)支持TWAIN和DirectShow接口,能直接搭配机器视觉领域各专业软件。
(5)提供个性化定制服务,最大化提升产品性能。
(6)提供SDK开发包及驱动程序,支持Window XP 32bit、Win7/win8 32/64bit和Linux操作系统。
二、应用:
(1)以客户的需求为出发点,开发和生产定制相机模组。
(2)产品广泛应用于电子目镜、工业检测内窥镜、图像识别、医用内窥镜、科研等领域。

行业分类 : 医疗电子
开发平台 :
交付形式 :
性能参数 :
应用场景 :